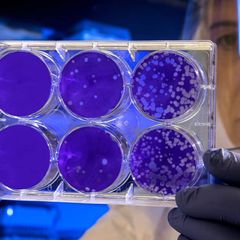

| |
Coronavirus Omicron News Review at 11 a.m. EST Daily
Coronavirus Omicron Current News:
https://www.inoreader.com/stream/user/1006407045/tag/CoronaVirus%20-%20Omicron/view/html?cs=m&sb=y
Selected Articles Review From The News And Times -
https://thenewsandtimes.blogspot.com/
Current Selected Articles: https://www.inoreader.com/stream/user/1006407045/tag/user-favorites/view/html
All Current Articles: https://www.inoreader.com/stream/user/1006407045/tag/all-articles/view/html |
|
 | Charles McGonigal and the October Surprise 2016 - Audio Review of the Selected Articles... |
| Audio Review of the Selected ArticlesCharles McGonigal and the October Surprise 2016 Google Search -... |
 The News And Times The News And Times | 2m | |
|
| How deadly has COVID been in 2023? Here's what the Ontario numbers are telling us... |
| How deadly has COVID been in 2023? Here's what the Ontario numbers are telling us Toronto Star |
 "COVID" - Google News "COVID" - Google News | 16m | |
|
| Novavax's Updated COVID-19 Vaccine Now Available in Sweden - Marketscreener.com |
| Novavax's Updated COVID-19 Vaccine Now Available in Sweden Marketscreener.com |
 "COVID" - Google News "COVID" - Google News | 1h | |
|
| Novavax : Updated COVID-19 Vaccine Now Available in Sweden - Marketscreener.com |
| Novavax : Updated COVID-19 Vaccine Now Available in Sweden Marketscreener.com |
 "COVID" - Google News "COVID" - Google News | 1h | |
|
| The Best Music Books of 2023: Lou Reed, Britney Spears, Sly Stone, Girls Groups and... |
| The Best Music Books of 2023: Lou Reed, Britney Spears, Sly Stone, Girls Groups and More Variety |
 "covid -19 origins" - Google News "covid -19 origins" - Google News | 2h | |
|
| Home Base: A very Veronica Christmas tradition - The Commercial Dispatch |
| Home Base: A very Veronica Christmas tradition The Commercial Dispatch |
 "covid -19 origins" - Google News "covid -19 origins" - Google News | 2h | |
|
| 'Wordle' #910 Answer, Hints and Tips for Saturday, December 16 ... - Newsweek |
| 'Wordle' #910 Answer, Hints and Tips for Saturday, December 16 ... Newsweek |
 "covid -19 origins" - Google News "covid -19 origins" - Google News | 3h | |
|
| COVID-19 and flu cases are rising in California. How bad will the holiday uptick... |
| COVID-19 and flu cases are rising in California. How bad will the holiday uptick be? Yahoo News |
 "COVID" - Google News "COVID" - Google News | 3h | |
|
| Do you need RSV vaccine, flu shot or COVID booster? How to sort through vaccination... |
| Do you need RSV vaccine, flu shot or COVID booster? How to sort through vaccination noise. Yahoo News |
 "COVID" - Google News "COVID" - Google News | 3h | |
|
| New COVID subvariant JN.1 sparks concerns. Should you be worried? Know symptoms and... |
| New COVID subvariant JN.1 sparks concerns. Should you be worried? Know symptoms and more Economic Times |
 "COVID" - Google News "COVID" - Google News | 3h | |
|
| Alcohol Intolerance After COVID: Symptoms, Causes, Treatment - Healthline |
| Alcohol Intolerance After COVID: Symptoms, Causes, Treatment Healthline |
 "COVID" - Google News "COVID" - Google News | 3h | |
|
| Hilary Duff Reveals She & Matthew Koma Have COVID Days After Pregnancy Announcement... |
| Hilary Duff Reveals She & Matthew Koma Have COVID Days After Pregnancy Announcement Yahoo Entertainment |
 "COVID" - Google News "COVID" - Google News | 3h | |
|
| COVID Cases Up In LA - Los Angeles - LAist |
| COVID Cases Up In LA - Los Angeles LAist |
 "COVID" - Google News "COVID" - Google News | 3h | |
|
| Healthful Hints: Saltwater gargling worth a try for COVID - La Crosse Tribune |
| Healthful Hints: Saltwater gargling worth a try for COVID La Crosse Tribune |
 "COVID" - Google News "COVID" - Google News | 4h | |
|
| New COVID-19 variant JN.1 spreading in China, US: Will it cause a surge in India?... |
| New COVID-19 variant JN.1 spreading in China, US: Will it cause a surge in India? How to protect yourself? The... |
 "COVID" - Google News "COVID" - Google News | 4h | |
|
| Hilary Duff Has COVID Days After Pregnancy Announcement - E! NEWS |
| Hilary Duff Has COVID Days After Pregnancy Announcement E! NEWS |
 "COVID" - Google News "COVID" - Google News | 4h | |
|
| California COVID, flu cases rise. Is a holiday surge coming? - Los Angeles Times |
| California COVID, flu cases rise. Is a holiday surge coming? Los Angeles Times |
 "COVID" - Google News "COVID" - Google News | 4h | |
|
| COVID-19 sub-strain JN.1 detected in Kerala - Rediff.com |
| COVID-19 sub-strain JN.1 detected in Kerala Rediff.com |
 "COVID" - Google News "COVID" - Google News | 4h | |
|
| COVID Map Shows 4 States With Higher Positive Cases - Newsweek |
| COVID Map Shows 4 States With Higher Positive Cases Newsweek |
 "COVID" - Google News "COVID" - Google News | 5h | |
|
| Pregnant Hilary Duff Reveals She and Husband Matthew Koma Have COVID After Family... |
| Pregnant Hilary Duff Reveals She and Husband Matthew Koma Have COVID After Family Disney Trip Yahoo... |
 "COVID" - Google News "COVID" - Google News | 6h | |
|
| Blood Type O May Be Associated with Higher Stroke Risk After COVID-19 Vaccination:... |
| Blood Type O May Be Associated with Higher Stroke Risk After COVID-19 Vaccination: Study | Weather.com The... |
 "COVID" - Google News "COVID" - Google News | 9h | |
|
| Was the Covid science wrong? What the Sunak documents tell us - Yahoo News |
| Was the Covid science wrong? What the Sunak documents tell us Yahoo News |
 "COVID" - Google News "COVID" - Google News | 9h | |
|
| Flu can cause persistent health problems similar to long Covid, study warns - South... |
| Flu can cause persistent health problems similar to long Covid, study warns South China Morning Post |
 "COVID" - Google News "COVID" - Google News | 9h | |
|
| RSV, flu and COVID cases on the rise in San Diego, but less people are getting vaccinated:... |
| RSV, flu and COVID cases on the rise in San Diego, but less people are getting vaccinated: county data NBC... |
 "COVID" - Google News "COVID" - Google News | 9h | |
|
| "The Big Fail": Learning from the COVID-19 pandemic - MSNBC |
| "The Big Fail": Learning from the COVID-19 pandemic MSNBC |
 "COVID" - Google News "COVID" - Google News | 10h | |
|
| Weekend podcast: actor Toby Jones, John Crace on Sunak at the Covid inquiry, and... |
| Weekend podcast: actor Toby Jones, John Crace on Sunak at the Covid inquiry, and how Taylor Swift gets... |
 "COVID" - Google News "COVID" - Google News | 10h | |
|
| A new COVID variant is spreading fast in the US. These are its most common symptoms... |
| A new COVID variant is spreading fast in the US. These are its most common symptoms Yahoo NewsCovid... |
 "COVID" - Google News "COVID" - Google News | 10h | |
|
| New book gives people suffering from Long COVID a voice - KTVU FOX 2 San Francisco |
| New book gives people suffering from Long COVID a voice KTVU FOX 2 San Francisco |
 "COVID" - Google News "COVID" - Google News | 11h | |
|
| 'It's getting worse' hospital warns as COVID and Influenza cases rise across the... |
| 'It's getting worse' hospital warns as COVID and Influenza cases rise across the region CambridgeToday |
 "COVID" - Google News "COVID" - Google News | 11h | |
|
| DEBRIEF: New COVID-19 concerns - WBAY |
| DEBRIEF: New COVID-19 concerns WBAY |
 "COVID" - Google News "COVID" - Google News | 12h | |
|
| State's top court takes up second case tied to UNC System COVID shutdowns - Carolina... |
| State's top court takes up second case tied to UNC System COVID shutdowns Carolina Journal |
 "COVID" - Google News "COVID" - Google News | 13h | |
|
| Florida's Surgeon General told the FDA that COVID vaccines aren't safe. The FDA calls... |
| Florida's Surgeon General told the FDA that COVID vaccines aren't safe. The FDA calls that misinformation. South... |
 "COVID" - Google News "COVID" - Google News | 13h | |
|
| A unique pathogenic mechanism of SARS-CoV-2 omicron variant: Selective induction... |
| A unique pathogenic mechanism of SARS-CoV-2 omicron variant: Selective induction of cellular senescence EurekAlert |
 "Omicron" - Google News "Omicron" - Google News | 13h | |
|
| newsGP - Interest spikes as new COVID-19 vaccines land - RACGP |
| newsGP - Interest spikes as new COVID-19 vaccines land RACGP |
 "XBB.1.5" - Google News "XBB.1.5" - Google News | 14h | |
|
| No Budget For COVID Vaccines Next Year; COVAX Donates Jabs Vs. Omicron XBB - One... |
| No Budget For COVID Vaccines Next Year; COVAX Donates Jabs Vs. Omicron XBB One News |
 "Omicron" - Google News "Omicron" - Google News | 14h | |
|
| Florida's surgeon general told the FDA that COVID-19 vaccines aren't safe. The FDA... |
| Florida's surgeon general told the FDA that COVID-19 vaccines aren't safe. The FDA calls that misinformation Herald... |
 "COVID" - Google News "COVID" - Google News | 14h | |
|
| Flu, RSV and Covid hospitalizations surging, CDC warns - NBC News |
| Flu, RSV and Covid hospitalizations surging, CDC warns NBC News |
 "COVID" - Google News "COVID" - Google News | 15h | |
|
| Senators Hold Up 43 Biden Diplomatic Nominees as Crises Roil World - The New York... |
| Senators Hold Up 43 Biden Diplomatic Nominees as Crises Roil World The New York Times |
 "covid -19 origins" - Google News "covid -19 origins" - Google News | 15h | |
|
| Hilary Duff tests positive for COVID-19 | Entertainment | myleaderpaper.com - Leader... |
| Hilary Duff tests positive for COVID-19 | Entertainment | myleaderpaper.com Leader Publications |
 "COVID" - Google News "COVID" - Google News | 16h | |
|
| COVID-19, flu continue to increase but CDC director believes US has hit peak of RSV... |
| COVID-19, flu continue to increase but CDC director believes US has hit peak of RSV WLS-TV |
 "COVID" - Google News "COVID" - Google News | 16h | |
|
| Need a Free COVID Test? Try Your Local Public Library - KQED |
| Need a Free COVID Test? Try Your Local Public Library KQED |
 "COVID" - Google News "COVID" - Google News | 16h | |
|
| COVID-19, flu continue to increase but CDC director believes US has hit peak of RSV... |
| COVID-19, flu continue to increase but CDC director believes US has hit peak of RSV KTRK-TV |
 "COVID" - Google News "COVID" - Google News | 17h | |
|
| COVID-19 still in Champaign County and tracked, but many cases go unreported - CU-CitizenAccess.org |
| COVID-19 still in Champaign County and tracked, but many cases go unreported CU-CitizenAccess.org |
 "COVID" - Google News "COVID" - Google News | 17h | |
|
| Pregnant Hilary Duff Reveals She and Husband Matthew Koma Have COVID - Us Weekly |
| Pregnant Hilary Duff Reveals She and Husband Matthew Koma Have COVID Us Weekly |
 "COVID" - Google News "COVID" - Google News | 17h | |
|
| HV.1 Emerges As Dominant COVID Variant Across The US - Quad-City Times |
| HV.1 Emerges As Dominant COVID Variant Across The US Quad-City Times |
 "COVID" - Google News "COVID" - Google News | 17h | |
|
| Video COVID and flu continue to increase: CDC - ABC News |
| Video COVID and flu continue to increase: CDC ABC News |
 "COVID" - Google News "COVID" - Google News | 17h | |
|
| Respiratory illness levels continue to climb ahead of holidays - University of Minnesota... |
| Respiratory illness levels continue to climb ahead of holidays University of Minnesota Twin Cities |
 "COVID" - Google News "COVID" - Google News | 17h | |
|
| Experts Are Concerned About COVID Vaccine Hesitancy Among Parents - The Times of... |
| Experts Are Concerned About COVID Vaccine Hesitancy Among Parents The Times of Northwest Indiana |
 "COVID" - Google News "COVID" - Google News | 17h | |
|
| Experts Are Concerned About COVID Vaccine Hesitancy Among Parents - WCF Courier |
| Experts Are Concerned About COVID Vaccine Hesitancy Among Parents WCF Courier |
 "COVID" - Google News "COVID" - Google News | 17h | |
|
| SALT Meat Market flavors Castle Rock area - The Fence Post |
| SALT Meat Market flavors Castle Rock area The Fence Post |
 "covid -19 origins" - Google News "covid -19 origins" - Google News | 17h | |
|
| American physical and mental health in shocking decline since COVID: Gallup poll... |
| American physical and mental health in shocking decline since COVID: Gallup poll New York Post |
 "COVID" - Google News "COVID" - Google News | 18h | |
|
| Carroll County delegation members predict funding challenges as COVID funding ends... |
| Carroll County delegation members predict funding challenges as COVID funding ends Baltimore Sun |
 "COVID" - Google News "COVID" - Google News | 18h | |
|
| Flu and COVID hospitalization rates climbing in Minnesota - MinnPost |
| Flu and COVID hospitalization rates climbing in Minnesota MinnPost |
 "COVID" - Google News "COVID" - Google News | 18h | |
|
| COVID and flu surge could strain hospitals as JN.1 variant grows, CDC warns - Yahoo... |
| COVID and flu surge could strain hospitals as JN.1 variant grows, CDC warns Yahoo Life |
 "COVID" - Google News "COVID" - Google News | 18h | |
|
| HV.1 Emerges As Dominant COVID Variant Across The US - The Dispatch Argus |
| HV.1 Emerges As Dominant COVID Variant Across The US The Dispatch Argus |
 "COVID" - Google News "COVID" - Google News | 18h | |
|
| Omicron Variant Uniquely Induces Cellular Senescence: Study - Mirage News |
| Omicron Variant Uniquely Induces Cellular Senescence: Study Mirage News |
 "Omicron" - Google News "Omicron" - Google News | 18h | |
|
 | Wisconsin DHS continues to make COVID-19 treatment easily available as cases climb... |
| La Crosse Tribune |
 "COVID" - Google News "COVID" - Google News | 18h | |
|
 | Homelessness in America reaches record level amid rising rents and end of COVID aid... |
| CBS News |
 "COVID" - Google News "COVID" - Google News | 18h | |
|
| In addition to long COVID, there's also long flu - Futurity: Research News |
| Futurity: Research News |
 "COVID" - Google News "COVID" - Google News | 18h | |
|
| HV.1 Emerges As Dominant COVID Variant Across The US - The Times of Northwest Indiana |
| HV.1 Emerges As Dominant COVID Variant Across The US The Times of Northwest Indiana |
 "COVID" - Google News "COVID" - Google News | 19h | |
|
| Know The Symptoms of JN.1, Fastest-Spreading Covid Variant - TODAY |
| Know The Symptoms of JN.1, Fastest-Spreading Covid Variant TODAY |
 "XBB.1.5" - Google News "XBB.1.5" - Google News | 19h | |
|
| Study: Solid organ transplant patients benefit from COVID-19 treatment - Medical... |
| Study: Solid organ transplant patients benefit from COVID-19 treatment Medical Xpress |
 "COVID" - Google News "COVID" - Google News | 19h | |
|
| LA finally buries 2,000 unclaimed individuals who died from Covid in 2020 - The Independent |
| LA finally buries 2,000 unclaimed individuals who died from Covid in 2020 The Independent |
 "COVID" - Google News "COVID" - Google News | 19h | |
|
| Long Covid makes me feel like I've disappeared from the world - 1News |
| Long Covid makes me feel like I've disappeared from the world 1News |
 "COVID" - Google News "COVID" - Google News | 19h | |
|
| Know The Symptoms of JN.1, Fastest-Spreading Covid Variant - TODAY |
| Know The Symptoms of JN.1, Fastest-Spreading Covid Variant TODAY |
 "XBB.1.5" - Google News "XBB.1.5" - Google News | 20h | |
|
| COVID's lost generation: NYC school kids still face devastating fallout - New York... |
| COVID's lost generation: NYC school kids still face devastating fallout New York Daily News |
 "COVID" - Google News "COVID" - Google News | 20h | |
|
| Latest Covid variant spreading fast — and more - WGN TV Chicago |
| Latest Covid variant spreading fast — and more WGN TV Chicago |
 "COVID" - Google News "COVID" - Google News | 20h | |
|
| COVID Making Its Way Through Central MN - WJON News |
| COVID Making Its Way Through Central MN WJON News |
 "COVID" - Google News "COVID" - Google News | 20h | |
|
| Bivalent COVID-19 Vaccine Confers Protection Against Symptomatic Omicron Infection... |
| Bivalent COVID-19 Vaccine Confers Protection Against Symptomatic Omicron Infection Hematology Advisor |
 "Omicron" - Google News "Omicron" - Google News | 20h | |
|
| Is it long COVID or long flu? Both illnesses have lingering symptoms, study says... |
| Is it long COVID or long flu? Both illnesses have lingering symptoms, study says Miami Herald |
 "COVID" - Google News "COVID" - Google News | 21h | |
|
| Inside Atlantic Station's plans to rebound from post-COVID office lull - The Atlanta... |
| Inside Atlantic Station's plans to rebound from post-COVID office lull The Atlanta Journal Constitution |
 "COVID" - Google News "COVID" - Google News | 21h | |
|
| Experts Are Concerned About COVID Vaccine Hesitancy Among Parents - Quad-City Times |
| Experts Are Concerned About COVID Vaccine Hesitancy Among Parents Quad-City Times |
 "COVID" - Google News "COVID" - Google News | 21h | |
|
| Oakley Capital Investments – Walking the walk - QuotedData |
| Oakley Capital Investments – Walking the walk QuotedData |
 "covid -19 origins" - Google News "covid -19 origins" - Google News | 21h | |
|
| Elevated COVID levels in Stateline, lower vaccination numbers - WREX.com |
| Elevated COVID levels in Stateline, lower vaccination numbers WREX.com |
 "COVID" - Google News "COVID" - Google News | 21h | |
|
| COVID Testing Company CareCube Was Vast Fraud, Feds Say - New York Magazine |
| COVID Testing Company CareCube Was Vast Fraud, Feds Say New York Magazine |
 "COVID" - Google News "COVID" - Google News | 21h | |
|
| Pregnant Hilary Duff, Husband Have Covid Days After Pregnancy Announcement - PEOPLE |
| Pregnant Hilary Duff, Husband Have Covid Days After Pregnancy Announcement PEOPLE |
 "COVID" - Google News "COVID" - Google News | 21h | |
|
| CDC warns providers of 'urgent' need to boost vaccination against COVID, flu, RSV... |
| CDC warns providers of 'urgent' need to boost vaccination against COVID, flu, RSV The Hill |
 "COVID" - Google News "COVID" - Google News | 21h | |
|
| China detects 7 infections of COVID subvariant JN.1; is this a variant of concern?... |
| China detects 7 infections of COVID subvariant JN.1; is this a variant of concern? Here are the details... |
 "COVID" - Google News "COVID" - Google News | 21h | |
|
| Capitol View commentary: Friday, December 15, 2023 - News Channel 5 Nashville |
| Capitol View commentary: Friday, December 15, 2023 News Channel 5 Nashville |
 "covid -19 origins" - Google News "covid -19 origins" - Google News | 22h | |
|
| Hilary Duff Shares COVID Diagnosis Days After Pregnancy Announcement - E! NEWS |
| Hilary Duff Shares COVID Diagnosis Days After Pregnancy Announcement E! NEWS |
 "COVID" - Google News "COVID" - Google News | 22h | |
|
| Too few Americans are getting vaccinated for flu, COVID & RSV, CDC warns - Medical... |
| Too few Americans are getting vaccinated for flu, COVID & RSV, CDC warns Medical Xpress |
 "COVID" - Google News "COVID" - Google News | 22h | |
|
| CDC warns providers of 'urgent' need to boost vaccination against COVID, flu, RSV... |
| CDC warns providers of 'urgent' need to boost vaccination against COVID, flu, RSV The Hill |
 "COVID" - Google News "COVID" - Google News | 22h | |
|
| HV.1 Emerges As Dominant COVID Variant Across The US - WCF Courier |
| HV.1 Emerges As Dominant COVID Variant Across The US WCF Courier |
 "COVID" - Google News "COVID" - Google News | 22h | |
|
| COVAX donating 1 million vaccines vs Omicron XBB - Philstar.com |
| COVAX donating 1 million vaccines vs Omicron XBB Philstar.com |
 "Omicron" - Google News "Omicron" - Google News | 22h | |
|
| Hugo Keith KC: dogged fact-finder at heart of Covid inquiry - The Guardian |
| Hugo Keith KC: dogged fact-finder at heart of Covid inquiry The Guardian |
 "COVID" - Google News "COVID" - Google News | 23h | |
|
| 2022 National Healthcare Spending Growth Slowed to Pre-COVID Levels - HealthPayerIntelligence.com |
| 2022 National Healthcare Spending Growth Slowed to Pre-COVID Levels HealthPayerIntelligence.com |
 "COVID" - Google News "COVID" - Google News | 23h | |
|
| VIDEO: How long COVID presents in children - Healio |
| VIDEO: How long COVID presents in children Healio |
 "COVID" - Google News "COVID" - Google News | 23h | |
|
| VIDEO: Understanding COVID seasonality and booster schedules - Healio |
| VIDEO: Understanding COVID seasonality and booster schedules Healio |
 "COVID" - Google News "COVID" - Google News | 23h | |
|
| VIDEO: Challenges of diagnosing long COVID in children - Healio |
| VIDEO: Challenges of diagnosing long COVID in children Healio |
 "COVID" - Google News "COVID" - Google News | 23h | |
|
| VIDEO: Latest COVID vaccination advancements for children - Healio |
| VIDEO: Latest COVID vaccination advancements for children Healio |
 "COVID" - Google News "COVID" - Google News | 23h | |
|
| VIDEO: Booster recommendations for children with long COVID - Healio |
| VIDEO: Booster recommendations for children with long COVID Healio |
 "COVID" - Google News "COVID" - Google News | 23h | |
|
| COVAX donating 1 million vaccines vs Omicron XBB - Philstar.com |
| COVAX donating 1 million vaccines vs Omicron XBB Philstar.com |
 "Omicron" - Google News "Omicron" - Google News | 23h | |
Comments
Post a Comment